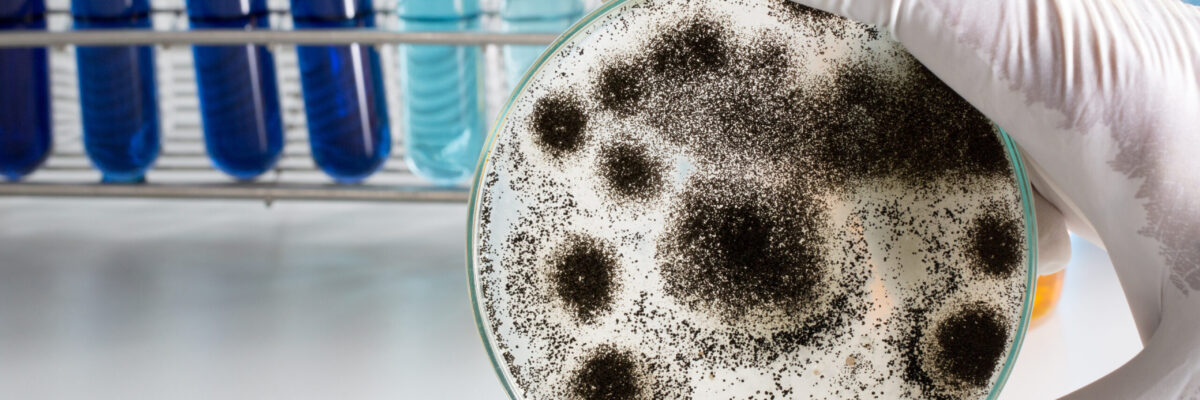

By Nicole Naggar, LEED GA, SFP
Most people breathe in mold spores every day without getting sick. After all, mold is ubiquitous and naturally found living both indoors and outdoors. The main issue is – although we can expect to find mold spores floating around in numbers and types indoors that are similar to those found in the outdoor air, we don’t want it growing indoors. As such, to help assess whether or not an indoor source is suspected, airborne mold spore samples that have been collected from indoor spaces are generally compared to the outdoor air (e.g., they should be similar in types and rank). When it grows indoors it can cause a variety of concerns, especially in hospitals and healthcare facilities. The main reason is because patients are present whose medical conditions or treatments may have compromised their immune systems, making them more susceptible to adverse health effects associated with elevated levels of airborne mold spores.
How Does Mold Begin to Grow?


Stained ceiling tiles, for instance, may seem like a minor problem that only impacts the visual quality of the space. However, the stain is typically the result of moisture that could be from a roof leak, plumbing leak, or even condensation. If you see a stain, oftentimes the backside of the ceiling tile will show signs of mold growth. As such, care should be taken when replacing any stained tile (or other water-damaged building material) to prevent releasing mold spores and to protect patients, staff, and visitors from unnecessary exposure.
Incentives Involved with the Control of Indoor Mold Growth
There are overwhelming incentives involved with managing moisture intrusion and mold in hospitals and healthcare facilities. Not only does mold cause structural damage costing money and potential lost revenue, but mold has been directly attributed to healthcare associated infections (HAIs). An HAI can cost a facility up to $60,000 for treatment and management, which directly impacts a facility’s budget. Sadly, research has shown that some HAIs have resulted in patient deaths which have been linked to exposures to elevated levels of airborne mold spores. Taking these consequences into consideration, hospitals and healthcare facilities are well incentivized to effectively manage the impact of mold and HAIs in their facilities.
Control and Prevention Efforts
So, what are healthcare facilities doing to prevent patients from getting sick from indoor mold growth? Special precautions may include:
HEPA filtering the air
- Giving patients with weakened immune systems antifungal medicine to prevent mold infections
- Placing sensitive patients in rooms where the airflow reduces the chances of the patient getting an infection
- Fixing water leaks and repairing damages as fast as possible
- Reducing dust during construction
- Tracking the number of patients with mold-associated infections to monitor for an increase, which could signal a problem with indoor mold growth.
Since hospitals and healthcare facilities are at an increased risk of indoor mold growth, it is crucial to take a proactive approach by ensuring that preventive measures are taken. Even some of the most basic preventive methods are effective and can include performing regular inspections and maintenance on all systems within the facility such as plumbing components, HVAC filters, ductwork, and condensate pans. Looking for stains, standing moisture, or materials that remain damp or wet are also prime areas of concern. Since water generally follows the path of least resistance, the inspection should take this into consideration and ensure that all areas and aspects are inspected, no matter how insignificant they may seem. Oftentimes a leak can originate at level five for example, but since water tends to settle at the bottom floor, level one or even the basement exhibits the most significant impact. Don’t forget that these affected areas may even be inside ductwork or hidden within wall and ceiling cavities. Finding and identifying the water source, and preventing or controlling the water intrusion, should be considered as the first steps in the investigation and mitigation process.
Consult with an Industrial Hygienist
It is important to be mindful of the fact that in order to avoid costly remediation associated with water-damaged building materials, it is crucial that moisture intrusion issues are addressed in a timely fashion. Every effort must be made to dry all affected building materials before mold growth begins to develop, which is generally within a 24 to 48-hour time period. It is also highly recommended that facility professionals consult with an Industrial Hygienist (IH) as soon as moisture intrusion occurs. Don’t wait! Drying efforts should be put into effect immediately. The IH should be consulted to conduct an initial inspection, provide recommendations for remediation (with oversight if necessary), and perform post-remediation visual and air “clearance” testing prior to build-back to ensure remediation efforts were effective.
Lastly, the moisture intrusion investigation and subsequent remediation process is a team effort. To avoid potential conflicts of interest and to ensure a successful outcome, it is in the client’s best interest to keep the recommendation, oversight, and scope development process (performed by Industrial Hygienists) separate from actual remediation (performed by qualified remediation contractors). Hiring two separate entities to perform these services will control potentially costly follow-ups later down the road.
Should you have any questions or need assistance, please contact Nicole Naggar at 310.850.5320 for more information.

HEPA filtering the air
HEPA filtering the air